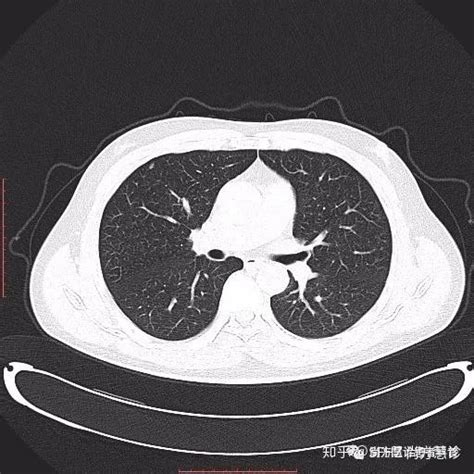

肺部有结节买保险之后能报销吗?
肺结节保险配置指南
肺结节是指肺部组织内直径小于3厘米的结节性病变,在体检或影像学检查中常常被发现。对于肺结节的诊断和治疗,保险配置起着重要作用。以下是肺结节保险配置的建议和指南:
在考虑保险配置之前,首先要了解肺结节的基本信息:
- 肺结节的大小、形状、位置等特征。
- 肺结节的性质,包括良性结节和恶性结节的鉴别。
- 已有的诊断结果和医生的建议。
针对肺结节疾病可能面临的治疗和费用方面的挑战,建议考虑以下几类保险:
- 重疾险:覆盖肺结节恶性化的治疗费用,包括手术、放疗、化疗等。
- 医疗保险:覆盖肺结节的诊断、治疗和后续随访费用,例如手术费用、药物费用、影像学检查费用等。
在配置肺结节保险时,要特别注意以下几个方面:
- 保险责任范围:确保保险公司明确覆盖肺结节的诊断、治疗和随访。
- 免赔额设置:了解保险合同中的免赔额设置,避免因免赔额过高而导致理赔困难。
在购买肺结节保险时,应当留意以下几点:
- 了解保险合同内容,包括保险金额、保险责任、赔付条件等。
- 根据个人情况选择适合的保险计划,确保覆盖范围和保费支付能力的平衡。
- 保持保险合同的及时更新和续保,避免因保险失效而导致的风险。
肺结节是一种常见的肺部疾病,对于保险配置需要根据个人健康状况、诊断结果和治疗计划等因素来考虑。选择合适的保险类型、了解保险责任和免赔额设置,以及注意购买时的细节,可以帮助您更好地应对肺结节疾病带来的风险和挑战。
免责声明:本网站部分内容由用户自行上传,若侵犯了您的权益,请联系我们处理,谢谢!联系QQ:2760375052